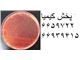
محیط کشت

اطلاعات تامین کننده
پخش کیمیا صنعتی
تهرانوارد کننده، عمده فروش
مواد شیمیایی آزمایشگاهی، مواد شیمیایی صنعتی، انواع محیط کشت میکروبی، انواع کیت های آزمایشگاهی، انواع شیشه آلات آزمایشگاهی، انواع وسایل یکبار مصرف آزمایشگاهی، انواع دستگاه و تجهیزات آزمایشگاهی، ساخت و نصب سکوهای آزمایشگاهی و شیرآلات آزمایشگاهی
مشاهده سایت فروشندهخرید از تامین کنندگان برتر پارس سنتر!

تامین کنندگان برتر پارس سنتر سرعت پاسخگویی بالاتر و محصولات بروز تری نسبت به سایر تامین کنندگان دارند.